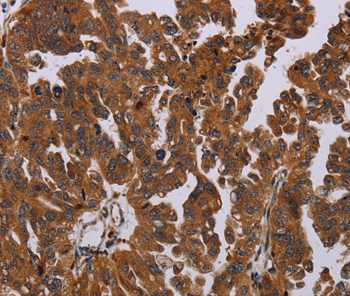

PAPPA Monoclonal Antibody
BSM-34258M
ApplicationsImmunoFluorescence, ELISA, ImmunoHistoChemistry, ImmunoHistoChemistry Frozen, ImmunoHistoChemistry Paraffin
Product group Antibodies
TargetPAPPA
Overview
- SupplierBioss Antibodies
- Product NamePAPPA Monoclonal Antibody
- Delivery Days Customer16
- ApplicationsImmunoFluorescence, ELISA, ImmunoHistoChemistry, ImmunoHistoChemistry Frozen, ImmunoHistoChemistry Paraffin
- Applications SupplierELISA(ELISA=1:30-3000), IHC-P(IHC-P=1:100-1:200), IHC-F(IHC-F=1:100-1:200), IF(IF=1:100-1:200)
- CertificationResearch Use Only
- ClonalityMonoclonal
- Clone ID2H5
- Concentration1 ug/ul
- ConjugateUnconjugated
- Gene ID5069
- Target namePAPPA
- Target descriptionpappalysin 1
- Target synonymsASBABP2; aspecific BCL2 ARE-binding protein 2; differentially placenta 1 expressed protein; DIPLA1; IGFBP-4ase; IGF-dependent IGFBP-4 protease; insulin-like growth factor-dependent IGF binding protein-4 protease; PAPA; PAPP-A; PAPPA1; pappalysin-1; pregnancy-associated plasma protein A, pappalysin 1
- HostMouse
- IsotypeIgG1
- Protein IDQ13219
- Protein NamePappalysin-1
- Storage Instruction-20°C
- UNSPSC12352203